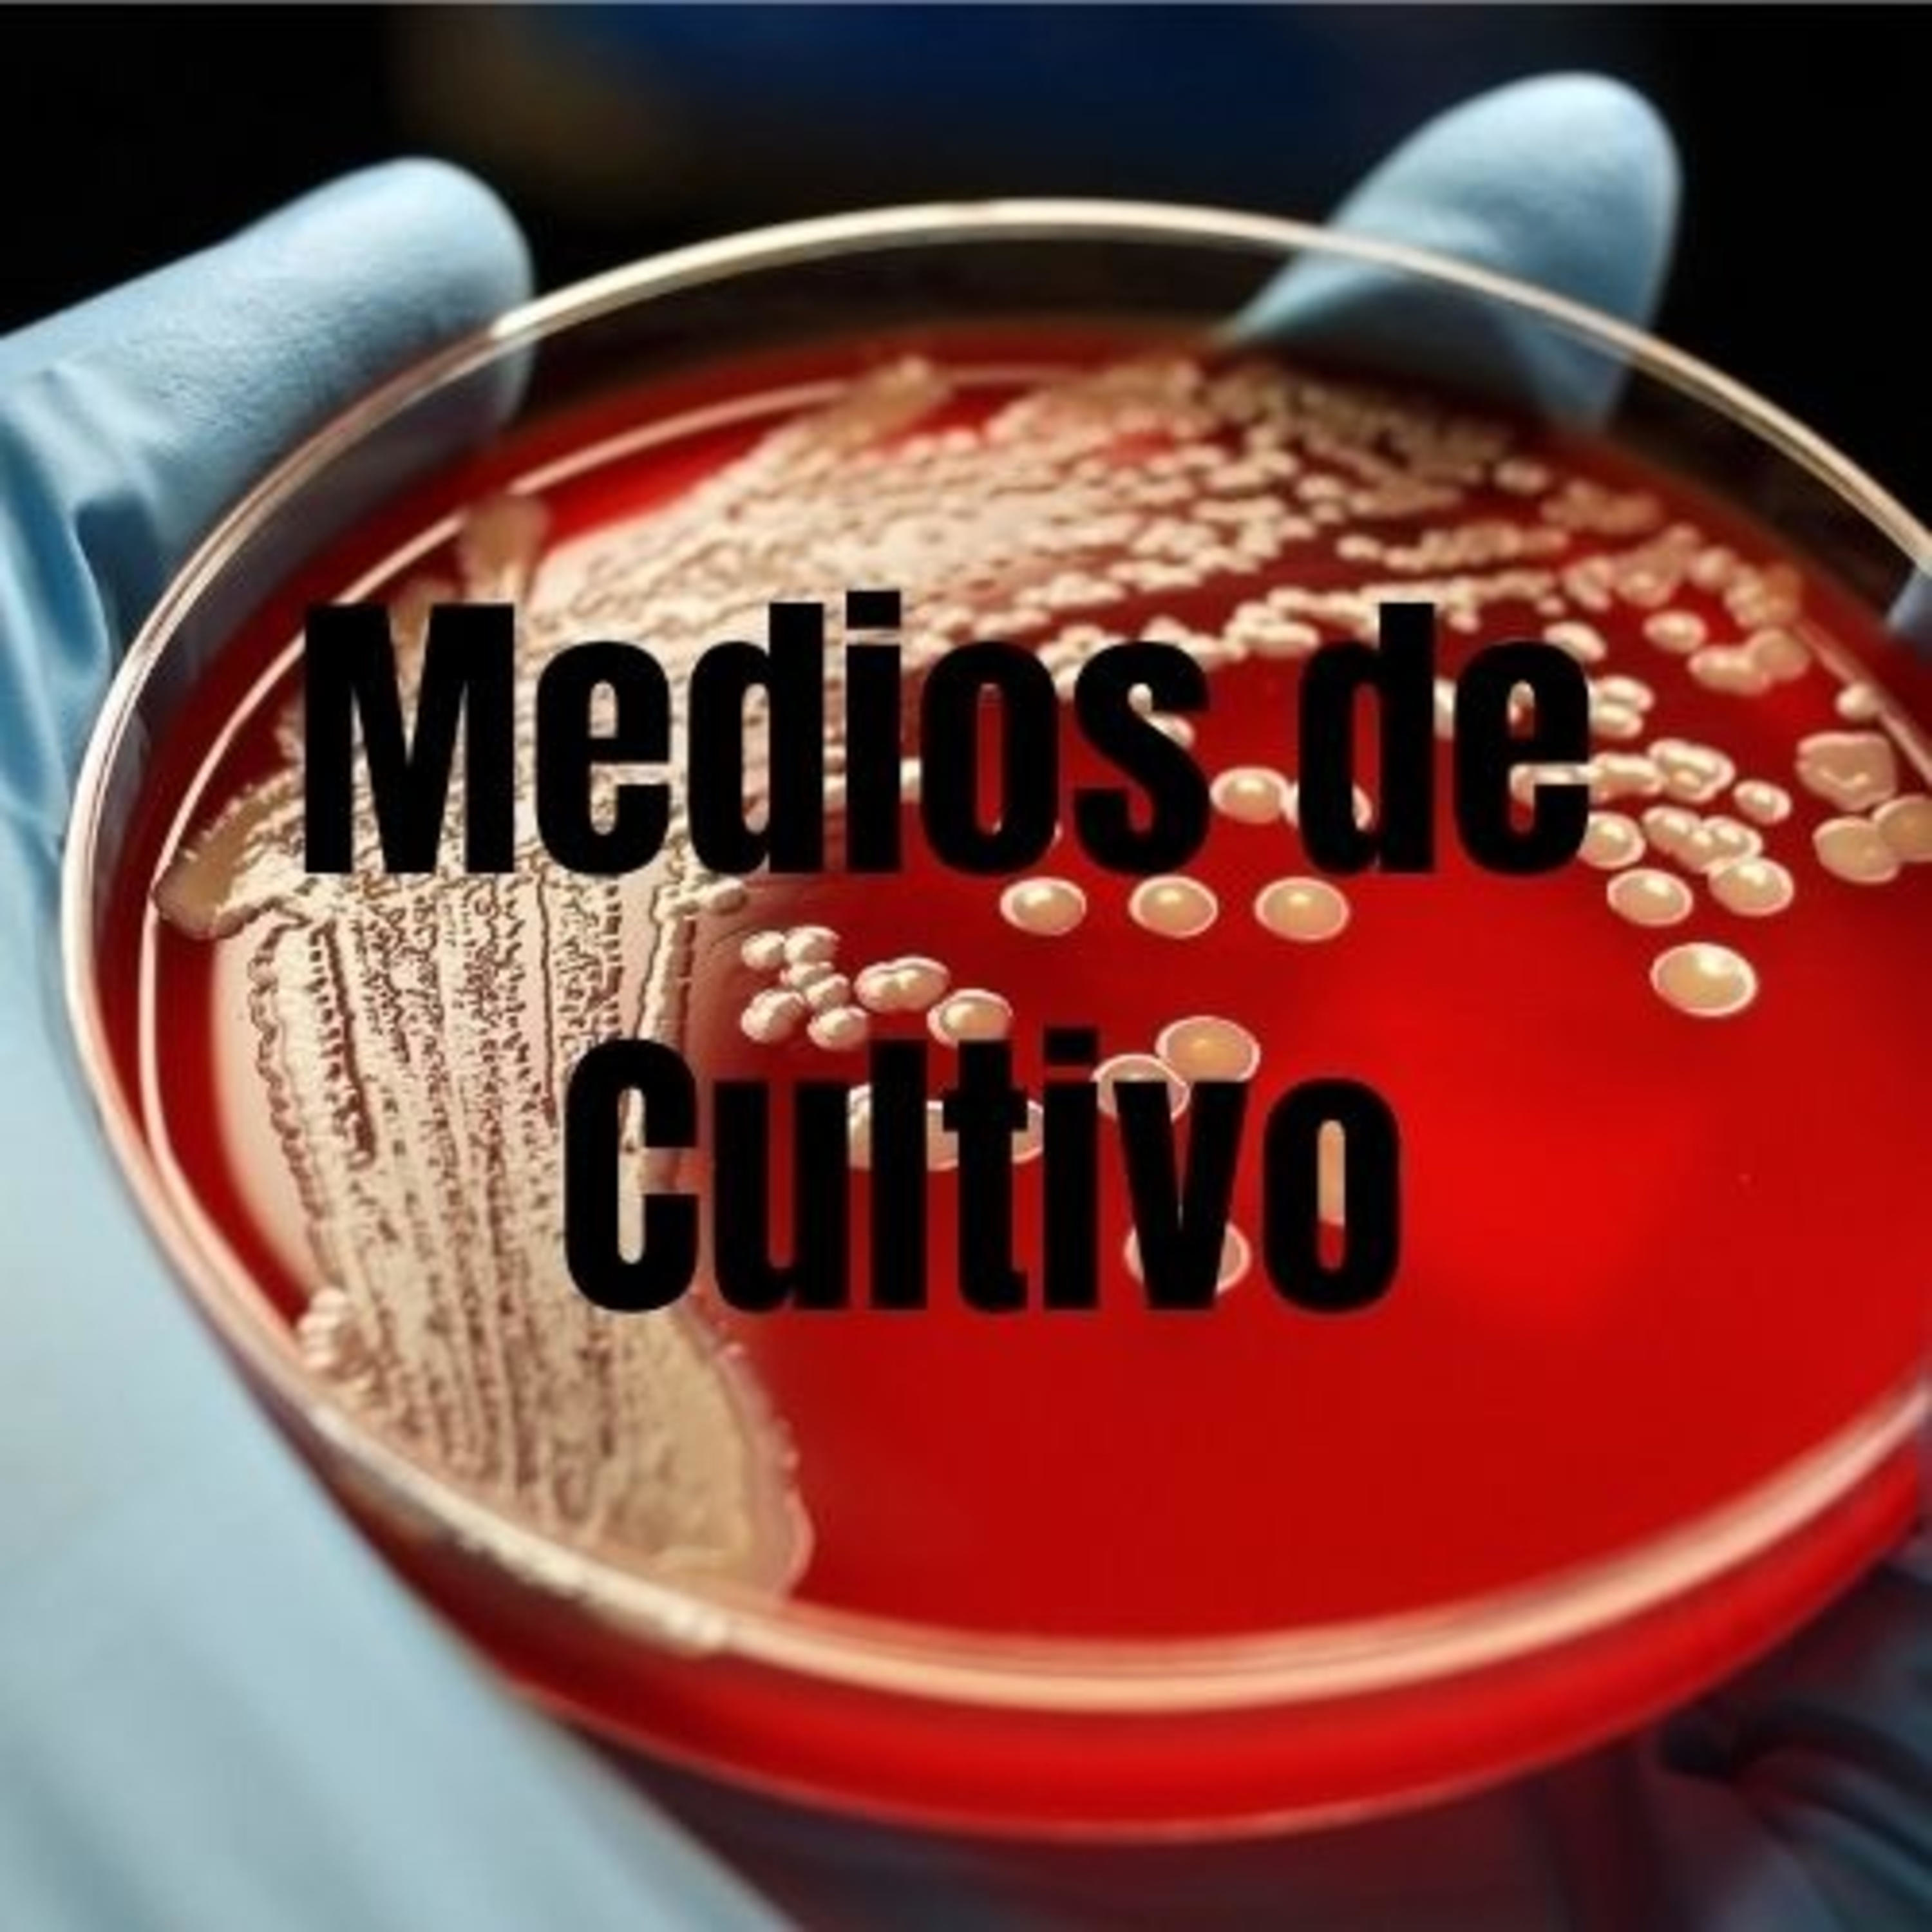
Medios de Cultivo

PODCAST · education
Medios de Cultivo
by Gerardo Hurtado Troche
Podcast de medios de cultivo por Gerardo Hurtado Troche
-
1
Podcast de Medios de Cultivo
Este podcast trata sobre los medios de cultivo, echo por Gerardo Hurtado Troche.
We're indexing this podcast's transcripts for the first time — this can take a minute or two. We'll show results as soon as they're ready.
No matches for "" in this podcast's transcripts.
No topics indexed yet for this podcast.
Loading reviews...
ABOUT THIS SHOW
Podcast de medios de cultivo por Gerardo Hurtado Troche
HOSTED BY
Gerardo Hurtado Troche
CATEGORIES
Loading similar podcasts...
Frequently Asked Questions
How many episodes does Medios de Cultivo have?
Medios de Cultivo currently has 1 episodes available on PodParley. New episodes are automatically indexed when they're published to the podcast feed.
What is Medios de Cultivo about?
Podcast de medios de cultivo por Gerardo Hurtado Troche
How often does Medios de Cultivo release new episodes?
Medios de Cultivo has 1 episodes. Check the episode list to see recent publication dates and frequency.
Where can I listen to Medios de Cultivo?
You can listen to Medios de Cultivo on PodParley by clicking any episode. We provide an embedded audio player for direct listening, and you can also subscribe via your preferred podcast app using the RSS feed.
Who hosts Medios de Cultivo?
Medios de Cultivo is created and hosted by Gerardo Hurtado Troche.
URL copied to clipboard!